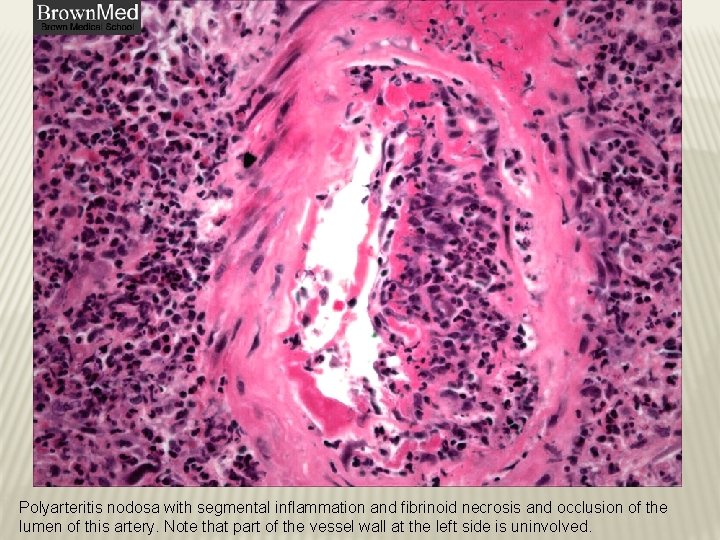
Polyarteritis nodosa with segmental inflammation and fibrinoid necrosis and occlusion of the lumen of Polyarteritis nodosa with segmental inflammation and fibrinoid necrosis and occlusion of the lumen of

VASCULITIS Sufia Husain Pathology Department KSU Riyadh April

- Slides: 25
VASCULITIS Sufia Husain Pathology Department KSU, Riyadh April 2015 Reference: Robbins & Cotran Pathology and Rubin’s Pathology
LECTURE OUTLINE Giant cell arteritis. Polyarteritis nodosa. Wegener's granulomatosis. Cutaneous hypersensitivity vasculitis and Henoch Schonlein purpura. Thromboangiitis obliterans (Burger’s disease)
VASCULITIS It is inflammation of vessel walls with many possible symptoms Causes: 1. It is usually immune-mediated v Immune complex deposition v Antineutrophil cytoplasmic antibodies (ANCAs) v Anti-endothelial cell antibodies v Autoreactive T cells 2. It can also be caused by infection, physical or chemical injury
GIANT-CELL (TEMPORAL) ARTERITIS Most common type of vasculitis Patients more than 50 yrs of age Female: Male = 2: 1. Chronic, granulomatous inflammation of large to small arteries, especially in head particularly the branches of the carotid artery (temporal a. and branches of the ophthalmic a. ) Involvment is segmental, acute and chronic.
CLINICAL FEATURES Symptoms : fever, facial pain or headache, often most intense along the course of the superficial temporal artery, Thickened and painful temporal artery Jaw pain Visual problems and acute vision loss The diagnosis depends on biopsy and histologic confirmation. Treatment: corticosteroids
GIANT-CELL (TEMPORAL) ARTERITIS: MORPHOLOGY Granulomatous inflammation of the blood vessel wall Giant cells Disruption and fragmentation of internal elastic lamina Proliferation of the intima with associated occlusion of the lumen. The healed stage reveals collagenous thickening of the vessel wall and the artery is transformed into a fibrous cord
POLYARTERITIS NODOSA Disease of young adults. there is segmental necrotizing inflammation of arteries of medium to small size, in any organ except the lungs. Most frequently kidneys (most common), heart, liver, and gastrointestinal tract. Polyarteritis nodosa has been associated with hepatitis B or hepatitis C virus infection.
POLYARTERITIS NODOSA Clinical manifestations result from ischemia and infarction of affected tissues and organs. Weakening of the arterial wall due to the inflammatory process may cause aneurysmal dilation or localized rupture. Fever, weight loss, abdominal pain and melena (bloody stool), muscular pain and neuritis. Renal arterial involvement is often prominent and is a major cause of death. Particularly characteristic of PAN is that all the different stages of activity ( i. e. active and chronic stages) may coexist in same artery or in different vessels at the same time. Fatal if untreated, but steroids and cyclophosphamide are curative.
Polyarteritis nodosa with segmental inflammation and fibrinoid necrosis and occlusion of the lumen of this artery. Note that part of the vessel wall at the left side is uninvolved.
WEGENER GRANULOMATOSIS is a necrotizing vasculitis characterized by the triad of 1) necrotizing granulomas of the upper and lower respiratory tract 2) necrotizing or granulomatous vasculitis of small to mediumsized vessels 3) renal disease in the form of necrotizing, crescentic, glomerulonephritis.
WEGENER GRANULOMATOSIS v Males are affected more often than females, at an average of about 40 years v C-ANCAs(antineutrophilic cytoplasmic antibodies) is positive in serum of more than 95% of patients. v Persistent pneumonitis , chronic sinusitis , mucosal ulcerations of the nasopharynx , and evidence of renal disease. v Untreated: fatal - may lead to death within 2 years if not treated.
Wegener granulomatosis: palatal ulceration
Wegener granulomatosis: palatal destruction
WG
WG
MICROSCOPIC POLYANGITIS/POLYARTERITIS It is a systemic small vessel vasculitis associated with glomerulonephritis. P-ANCA is characteristically present In the past it has been confused with leukocytoclastic vasculitis.
CHURG-STRAUSS SYNDROME ADDITIONAL READING Eosinophil-rich and granulomatous inflammation involving the respiratory tract and necrotizing vasculitis affecting small vessels Associated with asthma and blood eosinophilia Associated with p-ANCAs.
CUTANEOUS LEUKOCYTOCLASTIC OR HYPERSENSITIVITY VASCULITIS (ANGIITIS) Necrotizing vasculitis of arterioles, capillaries, venules. is inflammation of small blood vessels (commonly seen in the dermis of skin), characterized by palpable purpura. It is the most common vasculitis seen in clinical practice. Leukocytoclasis refers to the nuclear debris of infiltrating neutrophils in and around the vessels. All lesions tend to be of the same age. It affects many organs e. g. skin (most common), mucous membranes, lungs , brain, heart, GI , kidneys and muscle.
CUTANEOUS LEUKOCYTOCLASTIC OR HYPERSENSITIVITY VASCULITIS (ANGIITIS) Causes: Idiopathic immunologic reaction to an antigen that may present as Drugs e. g penicillin Infectious microrganisms e. g. strept. and other infections, heterlogous proteins, food products and toxic chemicals tumor antigens in various cancers. It may be a part of a systemic diseases e. g: a) collagen vascular diseases (lupus erythematosus, rheumatoid arthritis), b) Henoch-Schonlein purpura
CUTANEOUS LEUKOCYTOCLASTIC OR HYPERSENSITIVITY VASCULITIS (ANGIITIS) Skin biopsy is often diagnostic. Histologically there is infiltration of vessel wall with neutrophils, which become fragmented called as leukocytoclasia or nuclear dust.
Leukocytoclastic vasculitis in a skin biopsy showing fragmentation of neutrophil nuclei in and around vessel walls. Slide 12. 29
HENOCH-SCHONLEIN PURPURA (HSP) HSP is an Ig. A-mediated, autoimmune systemic disease, in which the small vessels show leukocytoclastic vasculitis. It causes skin purpura, arthritis, abdominal pain, gastrointestinal bleeding, orchitis and nephritis. The aetiology remains unknown. Immunoglobulin A (Ig. A) and complement component 3 (C 3) are deposited on arterioles, capillaries, and venules. Serum levels of Ig. A are high in HSP
THROMBOANGIITIS OBLITERANS (BUERGER DISEASE) characterized by segmental, thrombosing, acute and chronic inflammation of medium-sized and small arteries, principally of the leg and hands (tibial and radial arteries), with occasional secondary extension into adjacent veins and nerves. Buerger disease is a condition that occurs almost exclusively in heavy smokers of cigarettes, usually beginning before age 35. Tobacco either leads to direct toxicity to endothelium, or indices an immune response Clinical features include: pain in the affect hand or foot induced by exercise (called instep claudication). Patients tend to have pain even at rest, due to the neural involvement. Chronic ulcerations of the toes, or fingers may appear, followed in time by gangrene. Abstinence from cigarette smoking in the early stages of the disease brings relief from further attacks www. globalskinatlas. com
THROMBOANGIITIS OBLITERANS (BUERGER DISEASE) Microscopically, there is acute and chronic inflammation, accompanied by luminal thrombosis. The inflammatory process extends into adjacent veins and nerves (rare with other forms of vasculitis), and in time all three structures become encased in fibrous tissue.
SUMMARY OF VASCULITIDES Vessel Large Medium Small Disease comment Giant-cell arteritis >50 yr. Arteries of head. Takayasu arteritis F <40 yr. “Pulseless disease” Polyarteritis nodosa Young adults. Widespread. Kawasaki disease <4 yr. Coronary disease. Lymph nodes. Berger’s disease 35 yrs, smokers, extremities Wegener granulomatosis Lung, kidney. c-ANCA. Churg-Strauss syndrome Lung. Eosinophils. Asthma. p-ANCA. Microscopic polyangiitis Lung, kidney. p-ANCA. Cutaneous leukocytoclastic vasculitis Idiopathic, infectious, drugs, chemicals, cancer and systemic disease like HNP